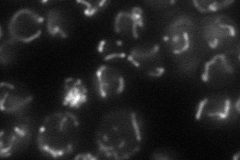
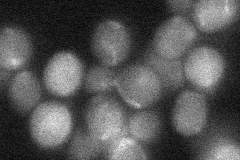
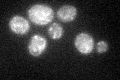
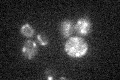

View description
Mitochondrial membrane protein that coordinates expression of mitochondrially-encoded genes; may facilitate delivery of mRNA to membrane-bound translation machinery
Localization:
Intensity:
Fold change:
Significance:
-
C’ GFP library in SD

mitochondria21.31 -
N' NOP1pr-GFP in SD
mitochondria38.213 -
N' TEF2pr-mCherry in SD

missing0 -
N' NATIVEpr-GFP in SD
mitochondria25.6792 -
N' TEF2pr-VC and Cyto-VN in SD

#N/A0 -
C’ GFP library in SD+DTT
mitochondria19.850.93No -
C’ GFP library in SD+H2O2

mitochondria23.151.08No -
C’ GFP library in Starvation Media
mitochondria21.811.02No -
C’ GFP library on the background of Pup2-DaMP

mitochondria -
C’ GFP library on the background of CCT mutant

mitochondria17.06980.800608No
